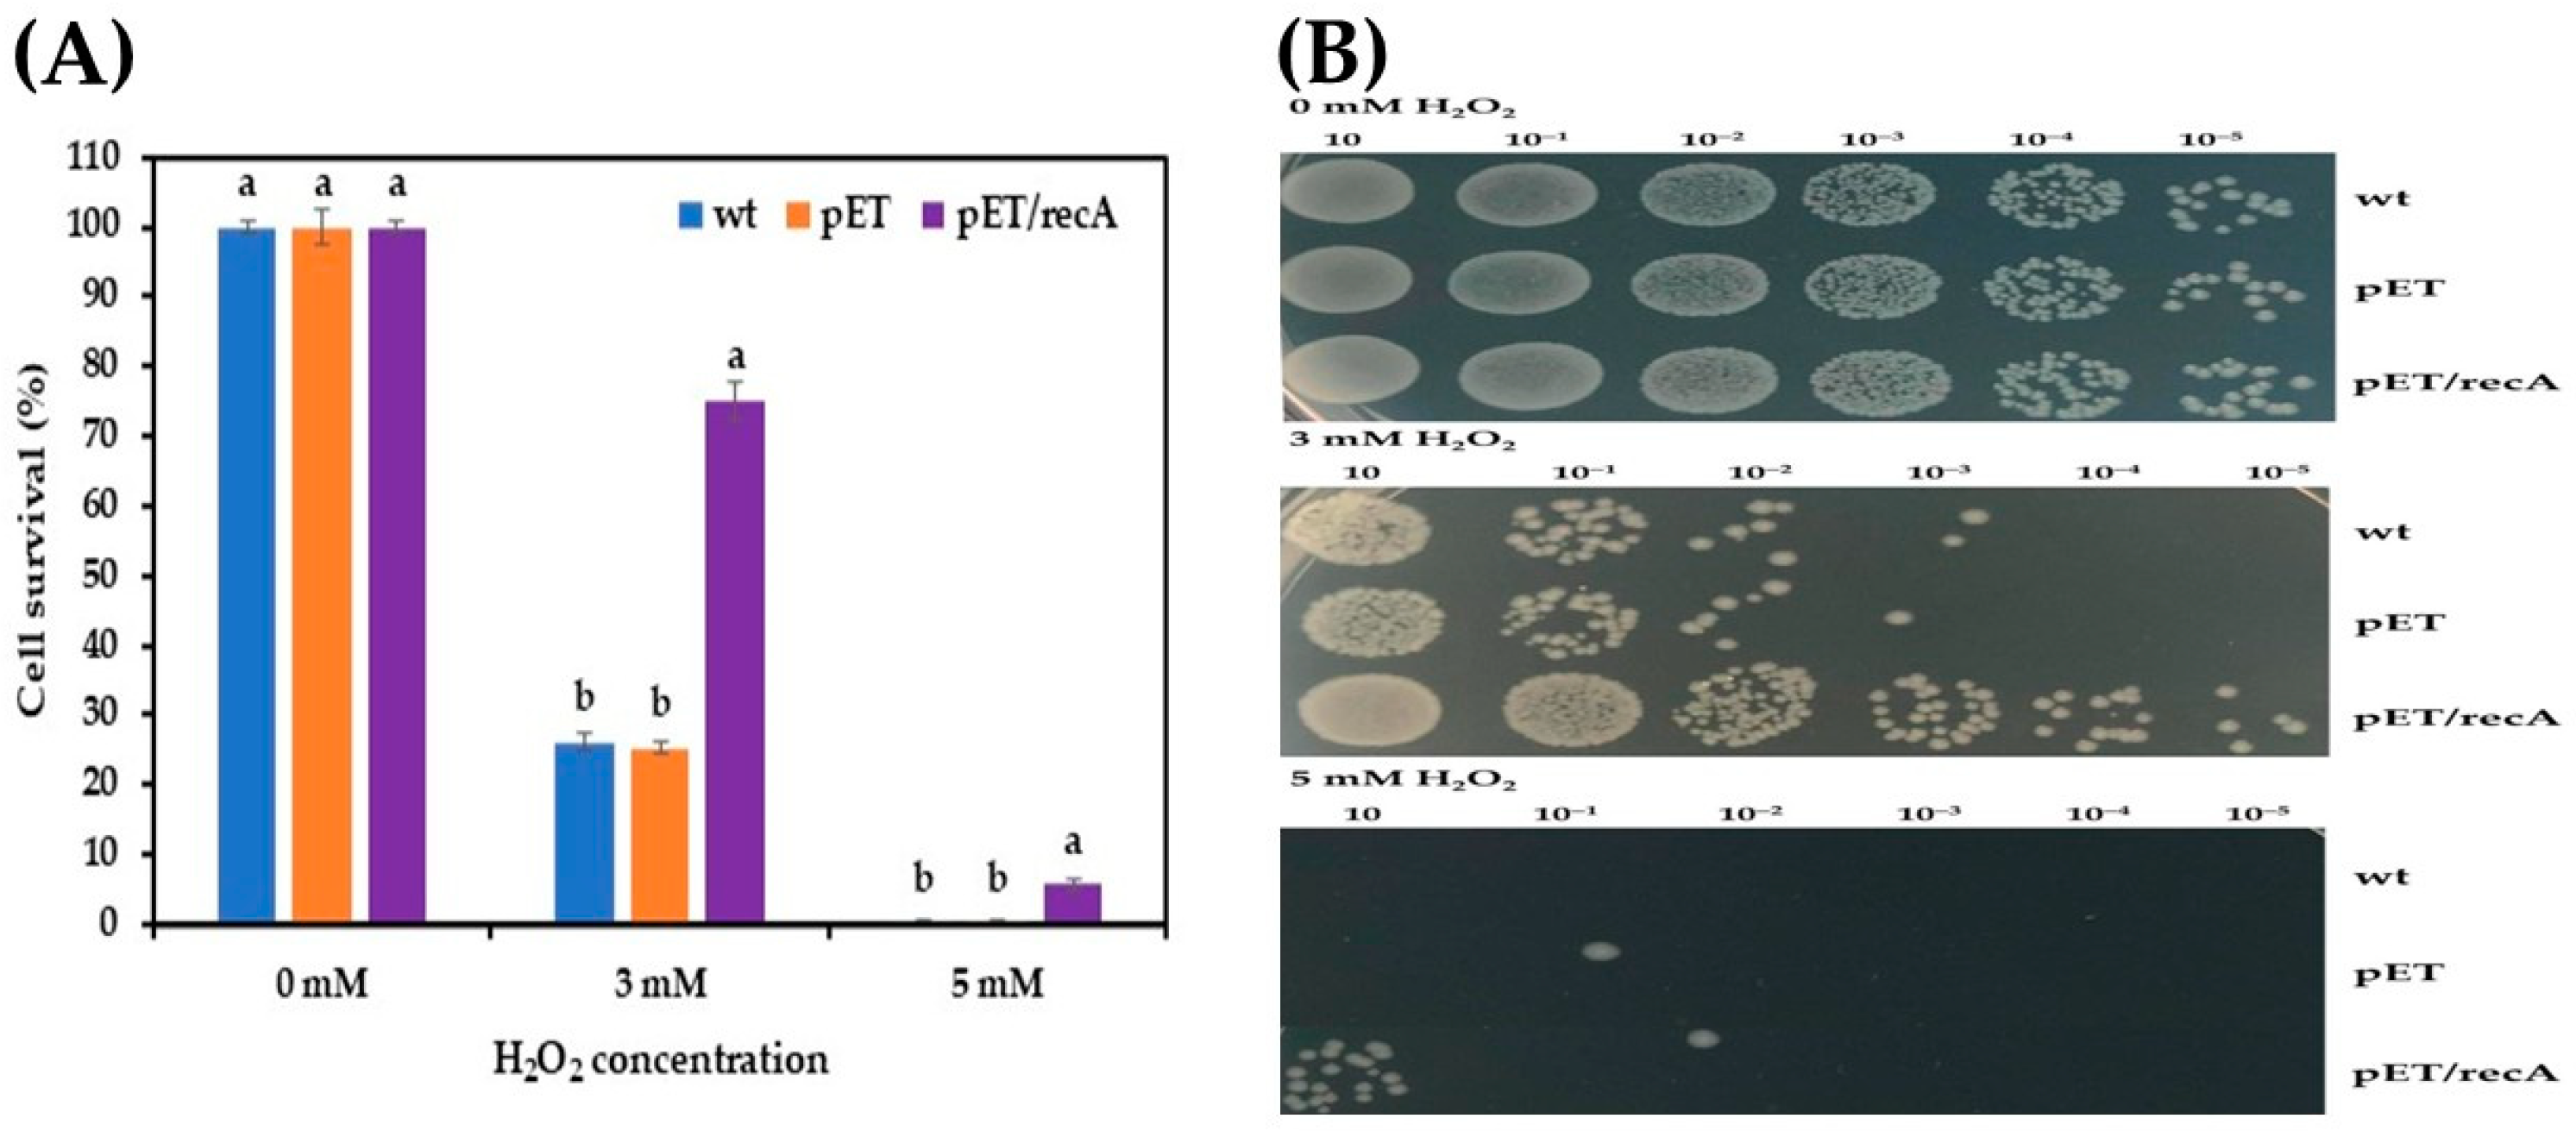
Fermentation 10 00617 g002
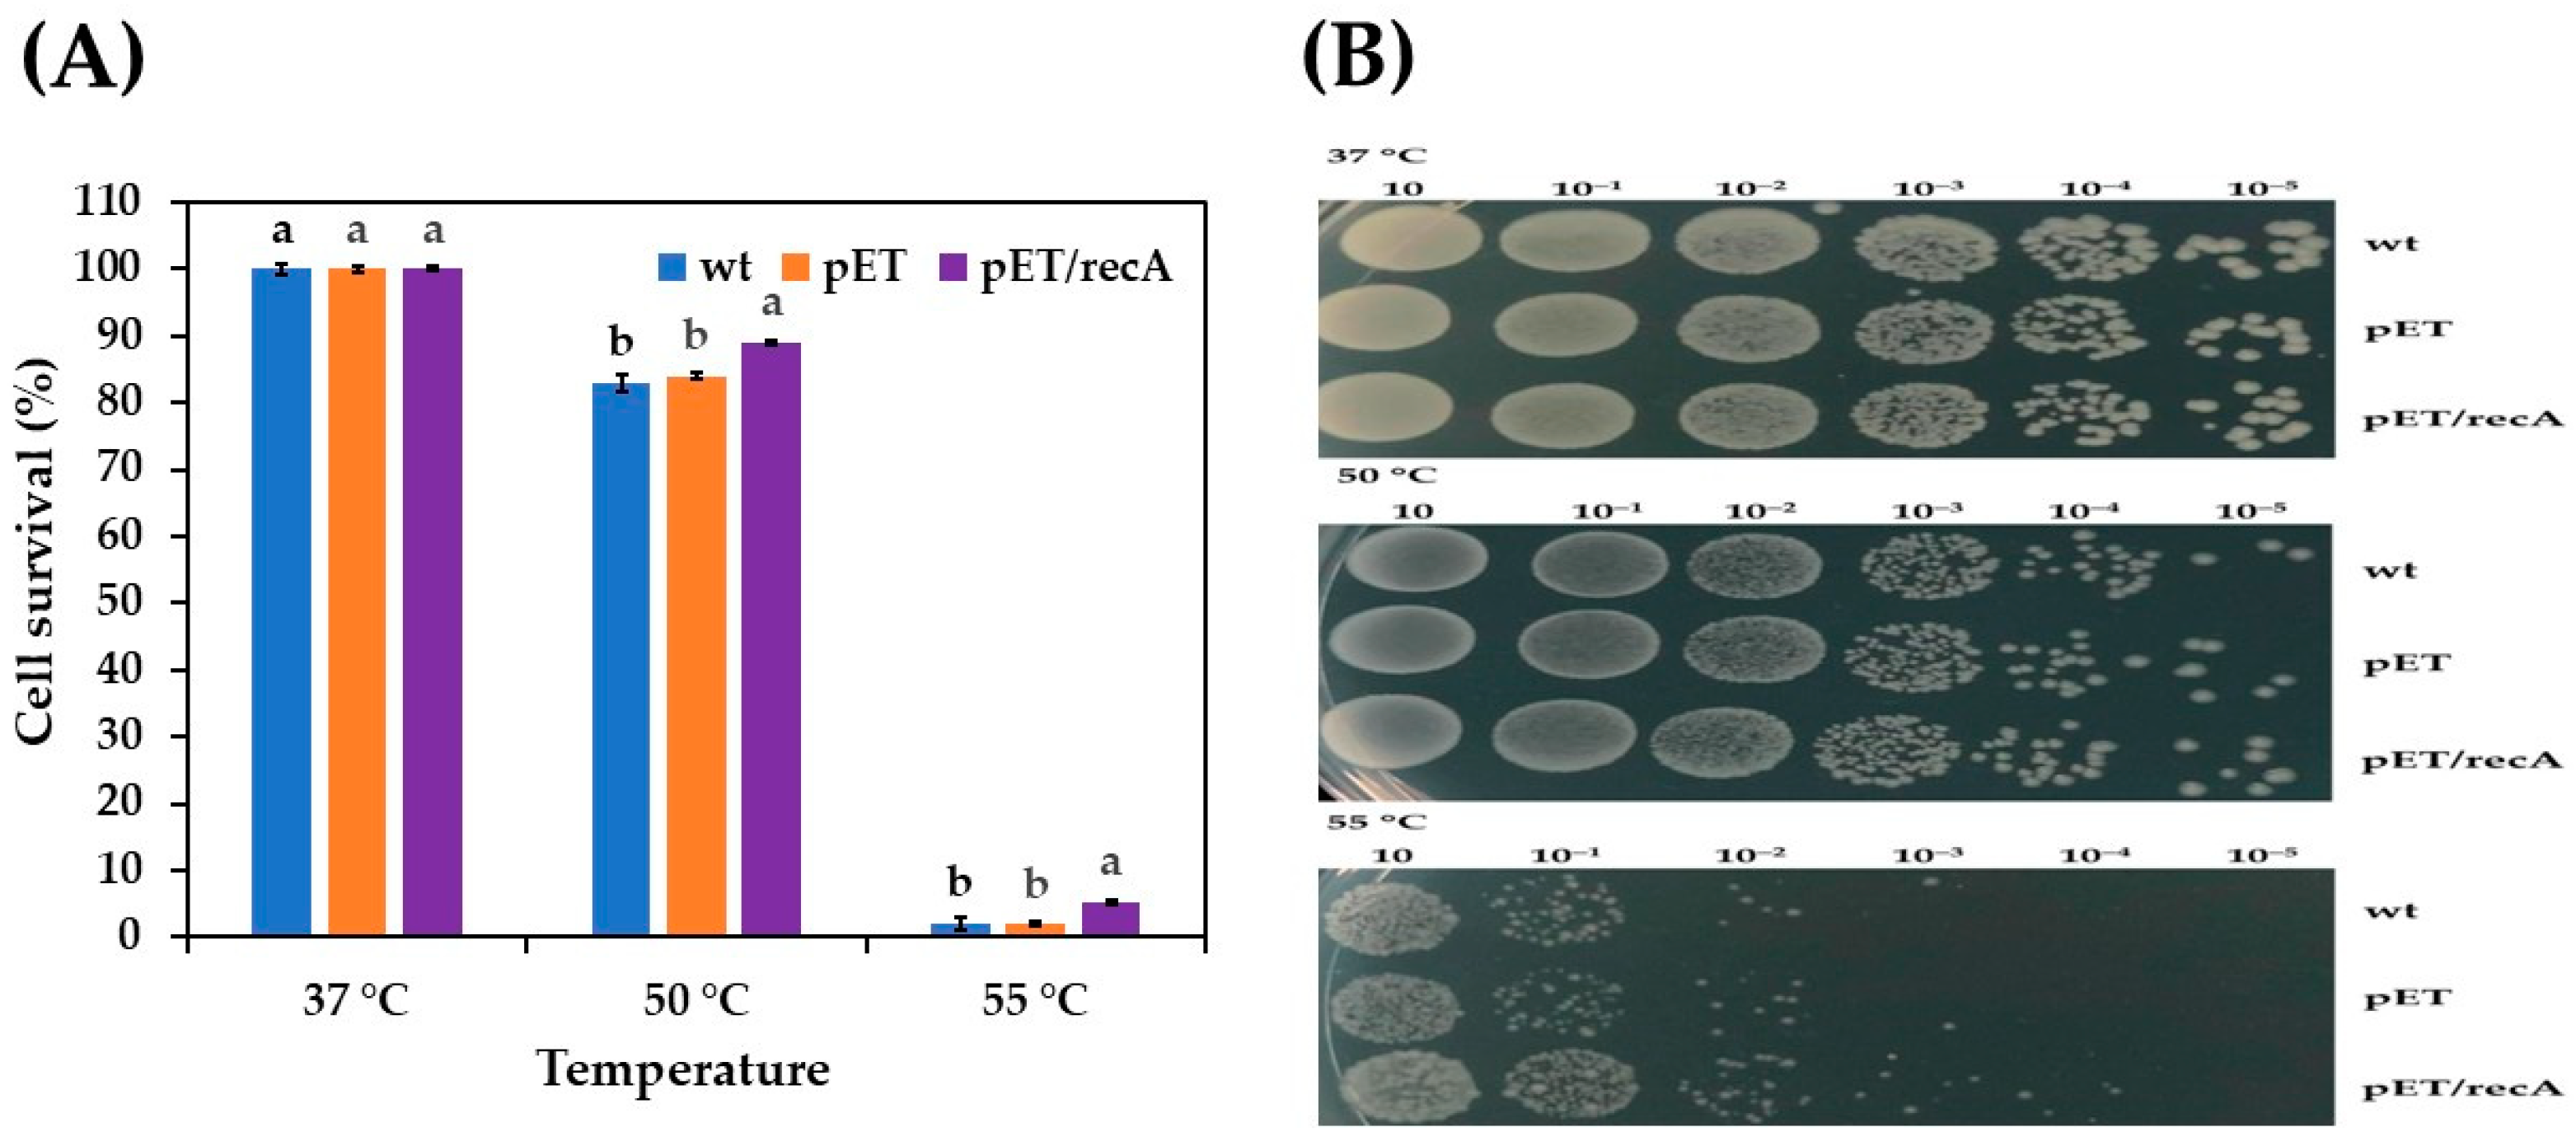
Fermentation 10 00617 g003
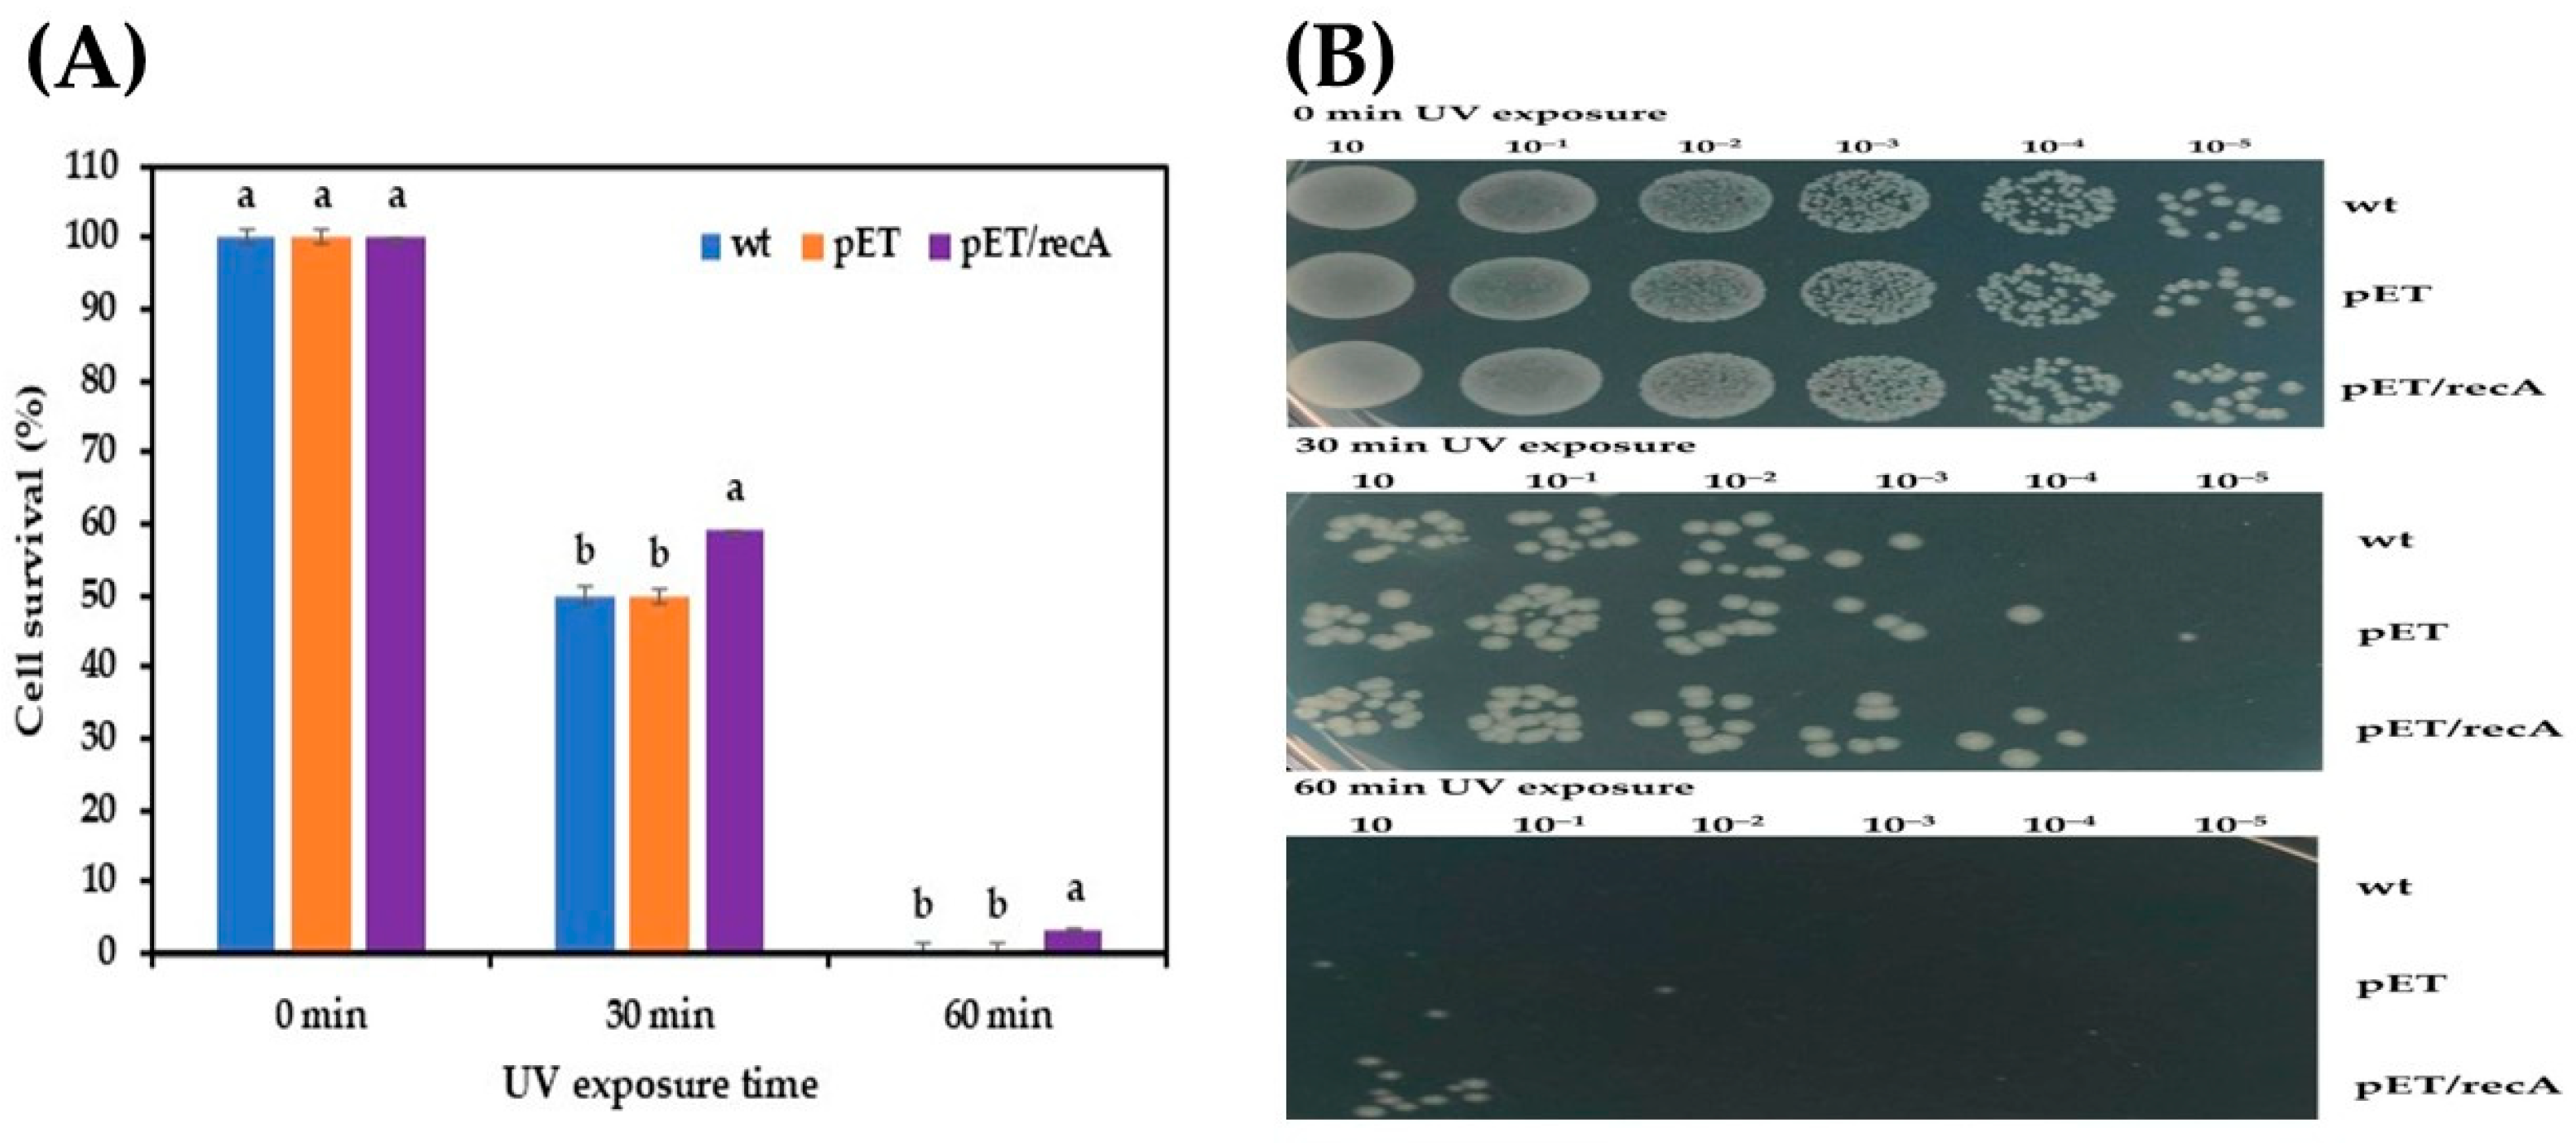
Fermentation 10 00617 g005

Enhanced Multi-Stress Tolerance in Escherichia coli via the Heterologous Expression of Zymomonas mobilis recA: Implications for Industrial Strain Engineering
Abstract
1. Introduction
2. Materials and Methods
2.1. Bacterial Strains and Growth Conditions
2.2. Genomic DNA Isolation and PCR Amplification of Z. mobilis recA Gene
2.3. Construction of Expression Vector and Gene Transformation
2.4. Protein Expression and SDS-PAGE Analysis
2.5. Stress Treatments of E. coli Recombinant Strains Harboring Z. mobilis recA Gene
2.6. Statistical Analysis
3. Results and Discussion
3.1. Cloning and Expression of recA Gene in E. coli
3.2. Effect of Stress Conditions on Growth of Recombinant E. coli pET-22b(+)-recA
4. Conclusions
Author Contributions
Funding
Institutional Review Board Statement
Informed Consent Statement
Data Availability Statement
Acknowledgments
Conflicts of Interest
References
- Podlesek, Z.; Žgur Bertok, D. The Escherichia coli SOS response: Much more than DNA damage repair. In Escherichia coli—Old and New Insights; Erjavec, M.S., Ed.; IntechOpen: London, UK, 2023. [Google Scholar]
- Bell, J.C.; Kowalczykowski, S.C. RecA: Regulation and mechanism of a molecular search engine. Trends Biochem. Sci. 2016, 41, 491–507. [Google Scholar] [CrossRef] [PubMed]
- Chatterjee, N.; Walker, G.C. Mechanisms of DNA damage, repair and mutagenesis. Environ. Mol. Mutagen. 2017, 58, 235. [Google Scholar] [CrossRef]
- Baharoglu, Z.; Mazel, D. SOS, the formidable strategy of bacteria against aggressions. FEMS Microbiol. Rev. 2014, 38, 1126–1145. [Google Scholar] [CrossRef]
- Recacha, E.; Machuca, J.; Díaz de Alba, P.; Ramos-Güelfo, M.; Docobo-Pérez, F.; Rodriguez-Beltrán, J.; Blázquez, J.; Pascual, A.; Rodríguez-Martínez, J.M. Quinolone resistance reversion by targeting the SOS response. mBio 2017, 8, e00971-17. [Google Scholar] [CrossRef] [PubMed]
- Yang, S.; Fei, Q.; Zhang, Y.; Contreras, L.M.; Utturkar, S.M.; Brown, S.D.; Himmel, M.E.; Zhang, M. Zymomonas mobilis as a model system for production of biofuels and biochemicals. Microb. Biotechnol. 2016, 9, 699–717. [Google Scholar] [CrossRef]
- Samappito, J.; Yamada, M.; Klanrit, P.; Thanonkeo, P. Characterization of a thermo-adapted strain of Zymomonas mobilis for ethanol production at high temperature. 3 Biotech 2018, 8, 474. [Google Scholar] [CrossRef] [PubMed]
- Sambrook, J.; Fritsch, E.R.; Maniatis, T. Molecular Cloning: A Laboratory Manual, 2nd ed.; Cold Spring Harbor Laboratory Press: Cold Spring Harbor, NY, USA, 1989. [Google Scholar]
- Sambrook, J.; Russell, D.W. Preparation and transformation of competent E. coli using calcium chloride. CSH Protoc. 2006, 1, pdb.prot3932. [Google Scholar]
- Thanonkeo, P.; Sootsuwan, K.; Laopaiboon, P.; Yamada, M. Magnesium ions improve growth and ethanol production of Zymomonas mobilis under heat or ethanol stress. Biotechnology 2007, 6, 112–119. [Google Scholar]
- Sezonov, G.; Joseleau-Petit, D.; D’Ari, R. Escherichia coli physiology in Luria-Bertani broth. J. Bacteriol. 2007, 189, 8746–8749. [Google Scholar] [CrossRef]
- Park, S.H.; Singh, H.; Appukuttan, D.; Jeong, S.; Choi, Y.J.; Jung, J.H.; Narumi, I.; Lim, S. PprM, a cold shock domain-containing protein from Deinococcus radiodurans, confers oxidative stress tolerance to Escherichia coli. Front. Microbiol. 2017, 7, 2124. [Google Scholar] [CrossRef]
- Shin, S.Y.; Kim, I.S.; Kim, Y.H.; Park, H.M.; Lee, J.Y.; Kang, H.G.; Yoon, H.S. Scavenging reactive oxygen species by rice dehydroascorbate reductase alleviates oxidative stresses in Escherichia coli. Mol. Cells 2008, 26, 616–620. [Google Scholar] [CrossRef] [PubMed]
- van der Veen, S.; van Schalkwijk, S.; Molenaar, D.; de Vos, W.M.; Abee, T.; Wells-Bennik, M.H.J. The SOS response of Listeria monocytogenes is involved in stress resistance and mutagenesis. Microbiology 2010, 156, 374–384. [Google Scholar] [CrossRef]
- Arsène, F.; Tomoyasu, T.; Bukau, B. The heat shock response of Escherichia coli. Int. J. Food Microbiol. 2000, 55, 3–9. [Google Scholar] [CrossRef]
- Chong, H.; Huang, L.; Yeow, J.; Wang, I.; Zhang, H.; Song, H.; Jiang, R. Improving ethanol tolerance of Escherichia coli by rewiring its global regulator cAMP receptor protein (CRP). PLoS ONE 2013, 8, e57628. [Google Scholar] [CrossRef]
- Ingram, L.O. Ethanol tolerance in bacteria. Crit. Rev. Biotechnol. 1990, 9, 305–319. [Google Scholar] [CrossRef]
- Aranda, J.; Bardina, C.; Beceiro, A.; Rumbo, S.; Cabral, M.P.; Barbé, J.; Bou, G. Acinetobacter baumannii RecA protein in repair of DNA damage, antimicrobial resistance, general stress response, and virulence. J. Bacteriol. 2011, 193, 3740–3747. [Google Scholar] [CrossRef]
- Herigstad, B.; Hamilton, M.; Heersink, J. How to optimize the drop plate method for enumerating bacteria. J. Microbiol. Methods. 2001, 44, 121–129. [Google Scholar] [CrossRef]
- Chen, H.; Hui, S.; Huang, M.; Xue, Y.; Yu, H. Bacillus velezensis LM2303 enhances plant drought tolerance by improving leaf water status and photosynthetic efficiency. J. Appl. Microbiol. 2018, 125, 1774–1785. [Google Scholar]
- Rodríguez-Rojas, A.; Kim, J.J.; Johnston, P.R.; Makarova, O.; Eravci, M.; Weise, C.; Hengge, R.; Rolff, J. Non-lethal exposure to H2O2 boosts bacterial survival and evolvability against oxidative stress. PLoS Genet. 2020, 16, e1008649. [Google Scholar] [CrossRef] [PubMed]
- Imlay, J.A.; Linn, S. Mutagenesis and stress responses induced in Escherichia coli by hydrogen peroxide. J. Bacteriol. 1987, 169, 2967–2976. [Google Scholar] [CrossRef] [PubMed]
- Buchmeier, N.A.; Lipps, C.J.; So, M.Y.; Heffron, F. Recombination-deficient mutants of Salmonella typhimurium are avirulent and sensitive to the oxidative burst of macrophages. Mol. Microbiol. 1993, 15, 1023–1030. [Google Scholar] [CrossRef] [PubMed]
- Duwat, P.; De Oliveira, R.; Ehrlich, S.D.; Boiteux, S. Repair of oxidative DNA damage in gram-positive bacteria: The Lactococcus lactis Fpg protein. Microbiology 1995, 141, 411–417. [Google Scholar] [CrossRef] [PubMed]
- Stohl, E.A.; Seifert, H.S. Neisseria gonorrhoeae DNA recombination and repair enzymes protect against oxidative damage caused by hydrogen peroxide. J. Bacteriol. 2006, 188, 7645–7651. [Google Scholar] [CrossRef]
- Sund, C.J.; Rocha, E.R.; Tzianabos, A.O.; Wells, W.G.; Gee, J.M.; Reott, M.A.; O’Rourke, D.P.; Smith, C.J. The Bacteroides fragilis transcriptome response to oxygen and H2O2: The role of OxyR and its effect on survival and virulence. Mol. Microbiol. 2008, 67, 129–142. [Google Scholar] [CrossRef]
- Bucur, F.I.; Grigore-Gurgu, L.; Crauwels, P.; Riedel, C.U.; Nicolau, A.I. Resistance of Listeria monocytogenes to stress conditions encountered in food and food processing environments. Front. Microbiol. 2018, 9, 417209. [Google Scholar] [CrossRef]
- Varmanen, P.; Savijoki, K. Responses of lactic acid bacteria to heat stress. In Stress Responses of Lactic Acid Bacteria. Food Microbiology and Food Safety; Tsakalidou, E., Papadimitriou, K., Eds.; Springer: Boston, MA, USA, 2011; pp. 55–66. [Google Scholar]
- Nicolaou, S.A.; Gaida, S.M.; Papoutsakis, E.T. Exploring the combinatorial genomic space in Escherichia coli for ethanol tolerance. Biotechnol. J. 2012, 7, 1337–1345. [Google Scholar] [CrossRef]
- Lovett, S.T. Replication arrest-stimulated recombination: Dependence on the RecA paralog, RadA/Sms and translesion polymerase, DinB. DNA Repair 2006, 5, 1421–1427. [Google Scholar] [CrossRef]
- Michel, B. After 30 years of study, the bacterial SOS response still surprises us. PLoS Biol. 2005, 3, 1174–1176. [Google Scholar] [CrossRef]
- Cox, M.M. Regulation of bacterial RecA protein function. Crit. Rev. Biochem. Mol. Biol. 2007, 42, 41–63. [Google Scholar] [CrossRef] [PubMed]
- Cao, H.; Wei, D.; Yang, Y.; Shang, Y.; Li, G.; Zhou, Y.; Ma, Q.; Xu, Y. Systems-level understanding of ethanol-induced stresses and adaptation in E. coli. Sci. Rep. 2017, 7, 44150. [Google Scholar] [CrossRef]
- Kaewchana, A.; Techaparin, A.; Boonchot, N.; Thanonkreo, P.; Klanrit, P. Improved high-temperature ethanol production from sweet sorghum juice using Zymomonas mobilis overexpressing groESL genes. Appl. Microbiol. Biotechnol. 2021, 105, 9419–9431. [Google Scholar] [CrossRef] [PubMed]
- Charoenpunthuwong, K.; Klanrit, P.; Chamnipa, N.; Thanonkeo, S.; Yamada, M.; Thanonkeo, P. Optimization condition for ethanol production from sweet sorghum juice by recombinant Zymomonas mobilis overexpressing groESL genes. Energies 2023, 16, 5284. [Google Scholar] [CrossRef]
- Luo, L.; Seo, P.S.; Seo, J.W.; Heo, S.Y.; Kim, D.H.; Kim, C. Improved ethanol tolerance in Escherichia coli by changing the cellular fatty acids composition through genetic manipulation. Biotechnol. Lett. 2009, 31, 1867–1871. [Google Scholar] [CrossRef] [PubMed]
- Kreuzer, K.N. DNA damage responses in prokaryotes: Regulating gene expression, modulating growth patterns, and manipulating replication forks. CSH Perspect. Biol. 2013, 5, a012674. [Google Scholar] [CrossRef]

Disclaimer/Publisher’s Note: The statements, opinions and data contained in all publications are solely those of the individual author(s) and contributor(s) and not of MDPI and/or the editor(s). MDPI and/or the editor(s) disclaim responsibility for any injury to people or property resulting from any ideas, methods, instructions or products referred to in the content. |
© 2024 by the authors. Licensee MDPI, Basel, Switzerland. This article is an open access article distributed under the terms and conditions of the Creative Commons Attribution (CC BY) license (https://creativecommons.org/licenses/by/4.0/).
Share and Cite
Phannarangsee, Y.; Kitwetcharoen, H.; Thanonkeo, S.; Klanrit, P.; Yamada, M.; Thanonkeo, P. Enhanced Multi-Stress Tolerance in Escherichia coli via the Heterologous Expression of Zymomonas mobilis recA: Implications for Industrial Strain Engineering. Fermentation 2024, 10, 617. https://doi.org/10.3390/fermentation10120617
Phannarangsee Y, Kitwetcharoen H, Thanonkeo S, Klanrit P, Yamada M, Thanonkeo P. Enhanced Multi-Stress Tolerance in Escherichia coli via the Heterologous Expression of Zymomonas mobilis recA: Implications for Industrial Strain Engineering. Fermentation. 2024; 10(12):617. https://doi.org/10.3390/fermentation10120617
Chicago/Turabian StylePhannarangsee, Yupaporn, Haruthairat Kitwetcharoen, Sudarat Thanonkeo, Preekamol Klanrit, Mamoru Yamada, and Pornthap Thanonkeo. 2024. "Enhanced Multi-Stress Tolerance in Escherichia coli via the Heterologous Expression of Zymomonas mobilis recA: Implications for Industrial Strain Engineering" Fermentation 10, no. 12: 617. https://doi.org/10.3390/fermentation10120617
APA StylePhannarangsee, Y., Kitwetcharoen, H., Thanonkeo, S., Klanrit, P., Yamada, M., & Thanonkeo, P. (2024). Enhanced Multi-Stress Tolerance in Escherichia coli via the Heterologous Expression of Zymomonas mobilis recA: Implications for Industrial Strain Engineering. Fermentation, 10(12), 617. https://doi.org/10.3390/fermentation10120617

